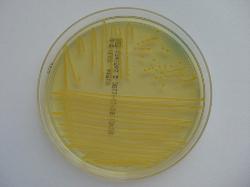

| Lactose negative colonies on CLED medium |
| Lactose positive colonies on CLED (24h incubation) |
CULTURAL CHARACTERISTICS
Escherichia coli - yellow, opaque colonies with a slightly deeper coloured centre.
Klebsiella spp. - mucoid colonies varying in colour from yellow to whitish-blue.
Proteus spp. - translucent blue colonies usually smaller than E. coli. Salmonella spp.
- flat blue colonies.
Pseudomonas aeruginosa green, matt colonies with rough margins.
Enterococcus faecalis - yellow colonies about 0.5 mm diameter .
Staphylococcus aureus - deep yellow colonies about 0.75 mm diameter.
Corynebacterium spp. & Lactobacillus spp. - very small grey colonies.
Escherichia coli - yellow, opaque colonies with a slightly deeper coloured centre.
Klebsiella spp. - mucoid colonies varying in colour from yellow to whitish-blue.
Proteus spp. - translucent blue colonies usually smaller than E. coli. Salmonella spp.
- flat blue colonies.
Pseudomonas aeruginosa green, matt colonies with rough margins.
Enterococcus faecalis - yellow colonies about 0.5 mm diameter .
Staphylococcus aureus - deep yellow colonies about 0.75 mm diameter.
Corynebacterium spp. & Lactobacillus spp. - very small grey colonies.
QUALITY CONTROL
Inoculate the medium and incubate for 18-24 hours at 35 - 37 °C.
Escherichia coli ATCC 25922 - very good growth, yellow colonies.
Proteus mirabilis ATCC 12453 - good growth; blue colonies; supressed swarming.
Staphylococcus aureus ATCC 25923 - good growth; yellow colonies.
Inoculate the medium and incubate for 18-24 hours at 35 - 37 °C.
Escherichia coli ATCC 25922 - very good growth, yellow colonies.
Proteus mirabilis ATCC 12453 - good growth; blue colonies; supressed swarming.
Staphylococcus aureus ATCC 25923 - good growth; yellow colonies.
COMPOSITION
Enzymatic Digest of Gelatin 4 g, Enzymatic Digest of Casein 4 g, Beef Extract 3 g,
Lactose 10 g, L-cystine 0.128 g, Bromothymol blue 0.02 g, Agar 15 g, Distilled water
ad 1000ml; adjust pH to 7.3 ± 0.2 (25 °C).
Sterilize by autoclaving at 121 ºC for 15 minutes. Results a blue-green coloured gel
after solidification.
Enzymatic Digest of Gelatin 4 g, Enzymatic Digest of Casein 4 g, Beef Extract 3 g,
Lactose 10 g, L-cystine 0.128 g, Bromothymol blue 0.02 g, Agar 15 g, Distilled water
ad 1000ml; adjust pH to 7.3 ± 0.2 (25 °C).
Sterilize by autoclaving at 121 ºC for 15 minutes. Results a blue-green coloured gel
after solidification.
DESCRIPTION
Medium is a non-inhibitory differential medium for the investigation of urinary infections. Cystine is added to support the organisms
which have a specific cystine requirement. Bromothymol blue is the pH indicator.
Lactose-positive germs form yellow colonies, lactose-negative germs form blue-green colonies. Medium inhibits the swarming of
Proteus by its electrolyte deficiency.
Medium is a non-inhibitory differential medium for the investigation of urinary infections. Cystine is added to support the organisms
which have a specific cystine requirement. Bromothymol blue is the pH indicator.
Lactose-positive germs form yellow colonies, lactose-negative germs form blue-green colonies. Medium inhibits the swarming of
Proteus by its electrolyte deficiency.
| CLED Agar Medium (Cystine-Lactose-Electrolyte Deficient ) |

(c) Costin Stoica
| Antibiogram |
| Encyclopedia |
| Culture media |
| Biochemical tests |
| Stainings |
| Images |
| Movies |
| Articles |
| Identification |
| Software |
| R E G N U M PROKARYOTAE |
| Back |